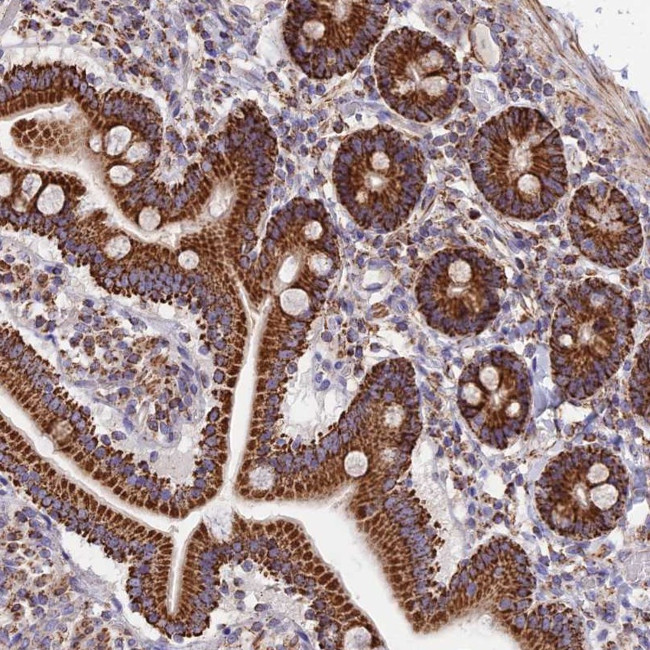
TTC4 Antibody in Immunohistochemistry (Paraffin) (IHC (P))

Search
Invitrogen
TTC4 Polyclonal Antibody
{{$productOrderCtrl.translations['antibody.pdp.commerceCard.promotion.promotions']}}
{{$productOrderCtrl.translations['antibody.pdp.commerceCard.promotion.viewpromo']}}
{{$productOrderCtrl.translations['antibody.pdp.commerceCard.promotion.promocode']}}: {{promo.promoCode}} {{promo.promoTitle}} {{promo.promoDescription}}. {{$productOrderCtrl.translations['antibody.pdp.commerceCard.promotion.learnmore']}}
产品信息
PA5-59983
种属反应
宿主/亚型
分类
类型
抗原
偶联物
形式
浓度
规格
纯化类型
保存液
内含物
保存条件
运输条件
RRID
产品详细信息
Immunogen sequence: LEMRAKADKL KRIEQRDVRK ANLKEKKERN QNEALLQAIK ARNIRLSEAA CEDEDSASEG LGELFLDGLS TENPHGARLS LDGQGRLSWP VLFLYP
Highest antigen sequence identity to the following orthologs: Mouse - 80%, Rat - 82%.
靶标信息
Effector protein for Rho-type GTPases. Regulates actin filament reorganization via its interaction with the Arp2/3 complex. Important for efficient actin polymerization. Possible regulator of lymphocyte and platelet function. Mediates actin filament reorganization and the formation of actin pedestals upon infection by pathogenic bacteria.
仅用于科研。不用于诊断过程。未经明确授权不得转售。
篇参考文献 (0)
生物信息学
蛋白别名: Hsp70/Hsp90 co-chaperone CNS1 homolog; Tetratricopeptide repeat protein 4; TPR repeat protein 4; unnamed protein product
基因别名: CNS1; My044; TTC4
UniProt ID: (Human) O95801
Entrez Gene ID: (Human) 7268